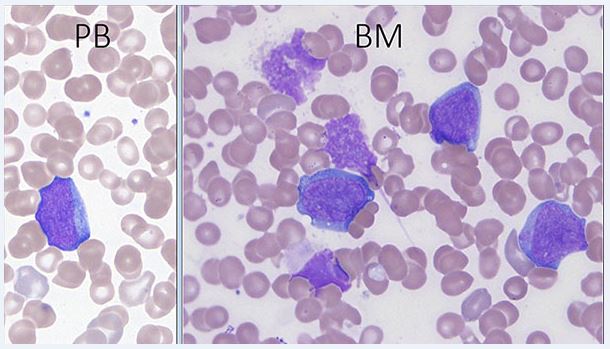

Myeloid proliferations associated with Down syndrome
Haematolymphoid Tumours (WHO Classification, 5th ed.)
| This page is under construction |
editContent Update To WHO 5th Edition Classification Is In Process; Content Below is Based on WHO 4th Edition ClassificationThis page was converted to the new template on 2023-12-07. The original page can be found at HAEM4:Transient Abnormal Myelopoiesis (TAM) Associated with Down Syndrome.Other relevent pages include: HAEM4:Transient Abnormal Myelopoiesis (TAM) Associated with Down Syndrome, HAEM4:Myeloid Leukemia Associated with Down Syndrome
Note: author needs to merge content from Transient Abnormal Myelopoiesis (TAM) Associated with Down Syndrome AND Myeloid Leukemia Associated with Down Syndrome
(General Instructions – The focus of these pages is the clinically significant genetic alterations in each disease type. This is based on up-to-date knowledge from multiple resources such as PubMed and the WHO classification books. The CCGA is meant to be a supplemental resource to the WHO classification books; the CCGA captures in a continually updated wiki-stye manner the current genetics/genomics knowledge of each disease, which evolves more rapidly than books can be revised and published. If the same disease is described in multiple WHO classification books, the genetics-related information for that disease will be consolidated into a single main page that has this template (other pages would only contain a link to this main page). Use HUGO-approved gene names and symbols (italicized when appropriate), HGVS-based nomenclature for variants, as well as generic names of drugs and testing platforms or assays if applicable. Please complete tables whenever possible and do not delete them (add N/A if not applicable in the table and delete the examples); to add (or move) a row or column in a table, click nearby within the table and select the > symbol that appears. Please do not delete or alter the section headings. The use of bullet points alongside short blocks of text rather than only large paragraphs is encouraged. Additional instructions below in italicized blue text should not be included in the final page content. Please also see Author_Instructions and FAQs as well as contact your Associate Editor or Technical Support.)
Primary Author(s)*
Linda D Cooley, MD, MBA, Children's Mercy Hospital, Kansas City, MO
WHO Classification of Disease
| Structure | Disease |
|---|---|
| Book | Haematolymphoid Tumours (5th ed.) |
| Category | Myeloid proliferations and neoplasms |
| Family | Myeloid neoplasms, secondary |
| Type | Myeloid neoplasms and proliferations associated with antecedent or predisposing conditions |
| Subtype(s) | Myeloid proliferations associated with Down syndrome |
Definition / Description of Disease
This is a distinct entity in the World Health Organization (WHO) classification system within the section of HAEM4:Myeloid Proliferations Associated with Down Syndrome[1].
Transient abnormal myelopoiesis (TAM) associated with Down syndrome (DS) is a unique disorder of newborns with DS that presents with clinical and morphological findings indistinguishable from those of acute myeloid leukemia. The blasts have morphological and immunological features of megakaryocytic lineage[1][2][3][4][5][6].
Synonyms / Terminology
Tansient myeloproliferative disorder (TMD)
Epidemiology / Prevalence
TAM is diagnosed in ~10% of newborns with DS, but the true incidence is higher because not all newborns are symptomatic. TAM uncommonly occurs in phenotypically normal neonates with trisomy 21 mosaicism, and is extremely rare in neonates without chromosome 21 abnormalities[1][2][3][4][5][6].
Clinical Features
Put your text here and fill in the table (Instruction: Can include references in the table. Do not delete table.)
| Signs and Symptoms | EXAMPLE: Asymptomatic (incidental finding on complete blood counts)
EXAMPLE: B-symptoms (weight loss, fever, night sweats) EXAMPLE: Fatigue EXAMPLE: Lymphadenopathy (uncommon) |
| Laboratory Findings | EXAMPLE: Cytopenias
EXAMPLE: Lymphocytosis (low level) |
editv4:Clinical FeaturesThe content below was from the old template. Please incorporate above.
Transient abnormal myelopoiesis occurs exclusively in patients with Down syndrome (constitutional trisomy 21), and affects approximately 4% to 10% of neonates. TAM manifests in the neonatal period, and is characterized by circulating megakaryoblasts with varied degrees of multisystem organ involvement. The median age of presentation is 3 to 7 days, though patients may be diagnosed at up to 2 months of life. The most common clinical manifestations include hepatomegaly (60%), splenomegaly (35%–40%), jaundice (15%), pericardial effusion (15%), pleural effusion (10%–15%), ascites (10%), respiratory distress (10%), and bleeding diathesis (10%). Less common features include hepatic fibrosis, hydrops fetalis, and renal failure. Characteristic hematologic findings include leukocytosis (WBC > 100K/μL in 20%–30%), thrombocytopenia (40%), and increased numbers of circulating blasts. Approximately 10% to 25% of patients are asymptomatic; thus, the diagnosis may be established as an incidental finding during laboratory assessment for some other cause. Occasionally, the finding of TAM may even be the first indication that a patient has trisomy 21.
The natural history of TAM is quite variable. Most neonates (80% with documented TAM) undergo spontaneous remission within 3 to 6 months of age. At the other end of the disease spectrum, neonatal (or even fetal) demise occurs in approximately 10% of patients secondary to diffuse organ infiltration by megakaryoblasts, associated parenchymal fibrosis, and subsequent multisystem failure. Independent risk factors that portend early mortality include WBC counts above 100 K/μL, preterm delivery (<37 weeks), effusions (pleural, pericardial, ascites, or hydrops), coagulopathy, bleeding diathesis, platelet count greater than 100K/μL, low birth weight, and failure to clear peripheral blasts. When these high-risk features are present, chemotherapeutic intervention is warranted.
Approximately 20% of patients with TAM develop AMKL within the first 4 years of life and this may be preceded by a myelodysplastic-like syndrome. The World Health Organization classification category “myeloid leukemia associated with DS” (DS-AMKL) encompasses both myelodysplastic and leukemic manifestations regardless of blast percentage. The median age of onset is 2 years, younger than that seen in non–DS-AMKL. Patients typically manifest with low WBC count, cytopenia, organomegaly, progressive marrow fibrosis, and clonal cytogenetic abnormalities, e.g., trisomy 8. Blasts in DS-AMKL are morphologically and immunophenotypically similar to those seen in TAM. Patients with DS-AMKL have a favorable prognosis with 80% 3-year overall survival. This response rate is, in part, attributed to enhanced chemosensitivity of megakaryoblasts to cytarabine. The cytidine deaminase gene functions in cytarabine catabolism, and its transcription is diminished in DS, which may lead to diminished intracellular drug metabolism and consequent increased drug efficacy[1][2][3][4][5].
End of V4 Section
Sites of Involvement
Blood and bone marrow are the principle sites of involvement. Extramedullary involvement, mainly of the spleen and liver, is almost always present as well[1].
Morphologic Features
The morphological and immunophenotypic features of TAM are similar to those seen in most cases of acute myeloid leukemia associated with DS[1]. Peripheral blood and bone marrow blasts often have basophilic cytoplasm and coarse basophilic granules and cytoplasmic blebbing suggestive of megakaryoblasts. Some patients have peripheral blood basophilia; erythroid and megakaryocytic dysplasia is often present in the bone marrow. No critical threshold has been established for blast percentage in the diagnosis of TAM. Circulating blasts can often be seen in both neonates without DS, especially those who are ill or premature, and neonates with DS, emphasizing the importance of manual peripheral smear review as well as ancillary laboratory studies in the evaluation [5]. Bone marrow examination may not be indicated as marrow findings are either similar to, or less pronounced than, those in blood[5].
Immunophenotype
Put your text here and fill in the table (Instruction: Can include references in the table. Do not delete table.)
| Finding | Marker |
|---|---|
| Positive (universal) | EXAMPLE: CD1 |
| Positive (subset) | EXAMPLE: CD2 |
| Negative (universal) | EXAMPLE: CD3 |
| Negative (subset) | EXAMPLE: CD4 |
editv4:ImmunophenotypeThe content below was from the old template. Please incorporate above.
Phenotypically, blasts commonly express stem cell (variable CD34, CD117), myeloid (CD13, CD33), nonlineage (CD4, CD7, CD56), and megakaryoblastic/megakaryocytic (CD61, CD41, CD42) antigens[5].
The blasts in TAM have a characteristic megakaryoblastic immunophenotype. In most cases, the leukemic blasts are positive for CD34, KIT (CD117), CD13, CD33, HLA-DR, CD4 (dim), CD41, CD42, CD110 (TPOR), IL3R, CD36, CD61, and CD71, often with expression of CD7 and CD56. The blasts are negative for MPO, CD15, CD14, CD11a, and glycophorin A. IHC with CD41, CD42b, and CD 61 may be particularly useful for identifying blasts of megakaryocytic lineage in BM biopsies[1].
End of V4 Section
WHO Essential and Desirable Genetic Diagnostic Criteria
(Instructions: The table will have the diagnostic criteria from the WHO book autocompleted; remove any non-genetics related criteria. If applicable, add text about other classification systems that define this entity and specify how the genetics-related criteria differ.)
| WHO Essential Criteria (Genetics)* | |
| WHO Desirable Criteria (Genetics)* | |
| Other Classification |
*Note: These are only the genetic/genomic criteria. Additional diagnostic criteria can be found in the WHO Classification of Tumours.
Related Terminology
(Instructions: The table will have the related terminology from the WHO autocompleted.)
| Acceptable | |
| Not Recommended |
Gene Rearrangements
Put your text here and fill in the table (Instructions: Details on clinical significance such as prognosis and other important information can be provided in the notes section. Please include references throughout the table. Do not delete the table.)
| Driver Gene | Fusion(s) and Common Partner Genes | Molecular Pathogenesis | Typical Chromosomal Alteration(s) | Prevalence -Common >20%, Recurrent 5-20% or Rare <5% (Disease) | Diagnostic, Prognostic, and Therapeutic Significance - D, P, T | Established Clinical Significance Per Guidelines - Yes or No (Source) | Clinical Relevance Details/Other Notes |
|---|---|---|---|---|---|---|---|
| EXAMPLE: ABL1 | EXAMPLE: BCR::ABL1 | EXAMPLE: The pathogenic derivative is the der(22) resulting in fusion of 5’ BCR and 3’ABL1. | EXAMPLE: t(9;22)(q34;q11.2) | EXAMPLE: Common (CML) | EXAMPLE: D, P, T | EXAMPLE: Yes (WHO, NCCN) | EXAMPLE:
The t(9;22) is diagnostic of CML in the appropriate morphology and clinical context (add reference). This fusion is responsive to targeted therapy such as Imatinib (Gleevec) (add reference). BCR::ABL1 is generally favorable in CML (add reference). |
| EXAMPLE: CIC | EXAMPLE: CIC::DUX4 | EXAMPLE: Typically, the last exon of CIC is fused to DUX4. The fusion breakpoint in CIC is usually intra-exonic and removes an inhibitory sequence, upregulating PEA3 genes downstream of CIC including ETV1, ETV4, and ETV5. | EXAMPLE: t(4;19)(q25;q13) | EXAMPLE: Common (CIC-rearranged sarcoma) | EXAMPLE: D | EXAMPLE:
DUX4 has many homologous genes; an alternate translocation in a minority of cases is t(10;19), but this is usually indistinguishable from t(4;19) by short-read sequencing (add references). | |
| EXAMPLE: ALK | EXAMPLE: ELM4::ALK
|
EXAMPLE: Fusions result in constitutive activation of the ALK tyrosine kinase. The most common ALK fusion is EML4::ALK, with breakpoints in intron 19 of ALK. At the transcript level, a variable (5’) partner gene is fused to 3’ ALK at exon 20. Rarely, ALK fusions contain exon 19 due to breakpoints in intron 18. | EXAMPLE: N/A | EXAMPLE: Rare (Lung adenocarcinoma) | EXAMPLE: T | EXAMPLE:
Both balanced and unbalanced forms are observed by FISH (add references). | |
| EXAMPLE: ABL1 | EXAMPLE: N/A | EXAMPLE: Intragenic deletion of exons 2–7 in EGFR removes the ligand-binding domain, resulting in a constitutively active tyrosine kinase with downstream activation of multiple oncogenic pathways. | EXAMPLE: N/A | EXAMPLE: Recurrent (IDH-wildtype Glioblastoma) | EXAMPLE: D, P, T | ||
editv4:Chromosomal Rearrangements (Gene Fusions)The content below was from the old template. Please incorporate above.
not applicable
End of V4 Section
editv4:Clinical Significance (Diagnosis, Prognosis and Therapeutic Implications).Please incorporate this section into the relevant tables found in:
- Chromosomal Rearrangements (Gene Fusions)
- Individual Region Genomic Gain/Loss/LOH
- Characteristic Chromosomal Patterns
- Gene Mutations (SNV/INDEL)
Transient abnormal myelopoiesis is a preleukemic disorder that occurs only in neonates with constitutional trisomy 21. Transient abnormal myelopoiesis typically presents in the first week of life with leukocytosis, thrombocytopenia, hepatomegaly, and circulating megakaryoblasts, the latter of which contain an acquired GATA1 mutation. Although TAM can be fatal in 10% of patients, it most often resolves spontaneously, but is believed to persist in a “quiescent” state. By 5 years of age, 20% of patients progress to AMKL following an intervening remission and/or a preceding myelodysplastic-like syndrome. Down syndrome–AMKL has a favorable prognosis with enhanced chemotherapeutic responsiveness to cytarabine.
The disease evolution of TAM and DS-AMKL is currently conceived as a sequential multistep process of leukemogenesis. Trisomy 21 represents the critical “initiating” event. GATA1 mutation reflects a “secondary hit” to fetal liver hematopoiesis, particularly megakaryocytic-erythroid progenitors, that leads to TAM and confers some selective advantage.
Given the risk of progression to DS-AMKL, some advocate that all neonates with DS undergo routine screening for TAM with manual peripheral blood smear review and GATA1 mutation analysis. With detection of a GATA1 mutation, clinical assessment and routine laboratory screening is then suggested periodically throughout early childhood[1][5].
End of V4 Section
Individual Region Genomic Gain/Loss/LOH
Put your text here and fill in the table (Instructions: Includes aberrations not involving gene rearrangements. Details on clinical significance such as prognosis and other important information can be provided in the notes section. Can refer to CGC workgroup tables as linked on the homepage if applicable. Please include references throughout the table. Do not delete the table.)
| Chr # | Gain, Loss, Amp, LOH | Minimal Region Cytoband and/or Genomic Coordinates [Genome Build; Size] | Relevant Gene(s) | Diagnostic, Prognostic, and Therapeutic Significance - D, P, T | Established Clinical Significance Per Guidelines - Yes or No (Source) | Clinical Relevance Details/Other Notes |
|---|---|---|---|---|---|---|
| EXAMPLE:
7 |
EXAMPLE: Loss | EXAMPLE:
chr7 |
EXAMPLE:
Unknown |
EXAMPLE: D, P | EXAMPLE: No | EXAMPLE:
Presence of monosomy 7 (or 7q deletion) is sufficient for a diagnosis of AML with MDS-related changes when there is ≥20% blasts and no prior therapy (add reference). Monosomy 7/7q deletion is associated with a poor prognosis in AML (add references). |
| EXAMPLE:
8 |
EXAMPLE: Gain | EXAMPLE:
chr8 |
EXAMPLE:
Unknown |
EXAMPLE: D, P | EXAMPLE:
Common recurrent secondary finding for t(8;21) (add references). | |
| EXAMPLE:
17 |
EXAMPLE: Amp | EXAMPLE:
17q12; chr17:39,700,064-39,728,658 [hg38; 28.6 kb] |
EXAMPLE:
ERBB2 |
EXAMPLE: D, P, T | EXAMPLE:
Amplification of ERBB2 is associated with HER2 overexpression in HER2 positive breast cancer (add references). Add criteria for how amplification is defined. | |
editv4:Genomic Gain/Loss/LOHThe content below was from the old template. Please incorporate above.
not applicable
End of V4 Section
Characteristic Chromosomal or Other Global Mutational Patterns
Put your text here and fill in the table (Instructions: Included in this category are alterations such as hyperdiploid; gain of odd number chromosomes including typically chromosome 1, 3, 5, 7, 11, and 17; co-deletion of 1p and 19q; complex karyotypes without characteristic genetic findings; chromothripsis; microsatellite instability; homologous recombination deficiency; mutational signature pattern; etc. Details on clinical significance such as prognosis and other important information can be provided in the notes section. Please include references throughout the table. Do not delete the table.)
| Chromosomal Pattern | Molecular Pathogenesis | Prevalence -
Common >20%, Recurrent 5-20% or Rare <5% (Disease) |
Diagnostic, Prognostic, and Therapeutic Significance - D, P, T | Established Clinical Significance Per Guidelines - Yes or No (Source) | Clinical Relevance Details/Other Notes |
|---|---|---|---|---|---|
| EXAMPLE:
Co-deletion of 1p and 18q |
EXAMPLE: See chromosomal rearrangements table as this pattern is due to an unbalanced derivative translocation associated with oligodendroglioma (add reference). | EXAMPLE: Common (Oligodendroglioma) | EXAMPLE: D, P | ||
| EXAMPLE:
Microsatellite instability - hypermutated |
EXAMPLE: Common (Endometrial carcinoma) | EXAMPLE: P, T | |||
editv4:Characteristic Chromosomal Aberrations / PatternsThe content below was from the old template. Please incorporate above.
Constitutional trisomy 21 or mosaic constitutional trisomy 21
End of V4 Section
Gene Mutations (SNV/INDEL)
Put your text here and fill in the table (Instructions: This table is not meant to be an exhaustive list; please include only genes/alterations that are recurrent or common as well either disease defining and/or clinically significant. If a gene has multiple mechanisms depending on the type or site of the alteration, add multiple entries in the table. For clinical significance, denote associations with FDA-approved therapy (not an extensive list of applicable drugs) and NCCN or other national guidelines if applicable; Can also refer to CGC workgroup tables as linked on the homepage if applicable as well as any high impact papers or reviews of gene mutations in this entity. Details on clinical significance such as prognosis and other important information such as concomitant and mutually exclusive mutations can be provided in the notes section. Please include references throughout the table. Do not delete the table.)
| Gene | Genetic Alteration | Tumor Suppressor Gene, Oncogene, Other | Prevalence -
Common >20%, Recurrent 5-20% or Rare <5% (Disease) |
Diagnostic, Prognostic, and Therapeutic Significance - D, P, T | Established Clinical Significance Per Guidelines - Yes or No (Source) | Clinical Relevance Details/Other Notes |
|---|---|---|---|---|---|---|
| EXAMPLE:EGFR
|
EXAMPLE: Exon 18-21 activating mutations | EXAMPLE: Oncogene | EXAMPLE: Common (lung cancer) | EXAMPLE: T | EXAMPLE: Yes (NCCN) | EXAMPLE: Exons 18, 19, and 21 mutations are targetable for therapy. Exon 20 T790M variants cause resistance to first generation TKI therapy and are targetable by second and third generation TKIs (add references). |
| EXAMPLE: TP53; Variable LOF mutations
|
EXAMPLE: Variable LOF mutations | EXAMPLE: Tumor Supressor Gene | EXAMPLE: Common (breast cancer) | EXAMPLE: P | EXAMPLE: >90% are somatic; rare germline alterations associated with Li-Fraumeni syndrome (add reference). Denotes a poor prognosis in breast cancer. | |
| EXAMPLE: BRAF; Activating mutations | EXAMPLE: Activating mutations | EXAMPLE: Oncogene | EXAMPLE: Common (melanoma) | EXAMPLE: T | ||
Note: A more extensive list of mutations can be found in cBioportal, COSMIC, and/or other databases. When applicable, gene-specific pages within the CCGA site directly link to pertinent external content.
editv4:Gene Mutations (SNV/INDEL)The content below was from the old template. Please incorporate above.
| Gene | Mutation | Oncogene/Tumor Suppressor/Other | Presumed Mechanism (LOF/GOF/Other; Driver/Passenger) | Prevalence (COSMIC/TCGA/Other) |
|---|---|---|---|---|
| GATA1 | Most mutations insert a premature termination codon either by introducing a stop codon or frameshift. Mutations affecting the splice site at GATA1 exon 2 exon/intron boundary are next most frequent. | zinc finger DNA-binding transcription factor that plays a critical role in the normal development of hematopoietic cell lineages | N-terminally truncating somatic mutation | 100% |
Other Mutations
Not applicable
End of V4 Section
Epigenomic Alterations
not applicable
Genes and Main Pathways Involved
Put your text here and fill in the table (Instructions: Please include references throughout the table. Do not delete the table.)
| Gene; Genetic Alteration | Pathway | Pathophysiologic Outcome |
|---|---|---|
| EXAMPLE: BRAF and MAP2K1; Activating mutations | EXAMPLE: MAPK signaling | EXAMPLE: Increased cell growth and proliferation |
| EXAMPLE: CDKN2A; Inactivating mutations | EXAMPLE: Cell cycle regulation | EXAMPLE: Unregulated cell division |
| EXAMPLE: KMT2C and ARID1A; Inactivating mutations | EXAMPLE: Histone modification, chromatin remodeling | EXAMPLE: Abnormal gene expression program |
editv4:Genes and Main Pathways InvolvedThe content below was from the old template. Please incorporate above.
In addition to trisomy 21, acquired GATA1 mutations are present in blast cells of TAM [1].
Somatic GATA1 mutations are pivotal in the development of TAM and have proven to be a marker of clonal identity in its evolution to DS-AMKL. The GATA1 gene is located on the X chromosome and encodes a zinc finger transcription factor that is essential for normal erythropoiesis and megakaryopoiesis. Its de novo protein product contributes to cytoplasmic maturation in megakaryocytes and organelle development in platelets, but functions as a negative regulator of megakaryocyte proliferation. Various acquired mutations in exon 2, or less commonly exon 3, ultimately yield a mutant N-terminally truncated GATA1 protein (designated GATA1s) that has been detected exclusively in patients with DS. GATA1 mutations (both single and multiple clones) have been detected in Guthrie card blood spots of patients with DS.
In normal human development, the liver is the primary site of fetal (in utero) hematopoiesis. With birth, the hepatic microenvironment changes such that liver hematopoiesis is down-regulated while bone marrow simultaneously assumes this primary functionality. Given the clinical and laboratory manifestations of TAM, which include leukocytosis and circulating megakaryoblasts, often with hepatomegaly, TAM reflects perturbation of this normal developmental process. Transient abnormal myelopoiesis may arise in utero within the fetal liver with “spontaneous resolution” reflecting the natural process of hepatic hematopoietic down-regulation.
TAM is the result of a multistep process in which trisomy 21 is the “initiating” event in disease pathogenesis. Trisomy 21 creates an environment, in utero, in which hematopoietic progenitor cells within fetal liver are primed for acquisition of either single or multiple somatic GATA1 mutations that reflect a “secondary hit,” thereby promoting hematopoietic dysregulation and emergence of TAM. With birth, hematopoiesis naturally transitions from fetal liver to bone marrow and the GATA1 megakaryoblastic clone becomes quiescent. However, this clone persists over time and undergoes other somatic mutations and epigenetic events ultimately lead to the impaired megakaryocytic differentiation and uncontrolled proliferation characteristic of DS-AMKL[2][3][4][5].
End of V4 Section
Genetic Diagnostic Testing Methods
When TAM is suspected clinically, cytogenetic karyotypic analysis should be performed to establish constitutional trisomy 21, while GATA1 mutation analysis is also recommended to document clonality of the blast population. The presence of an acquired mutation(s) in exon 2 or exon 3 of the GATA1 gene on chromosome X establishes a diagnosis of TAM and serves as a potential marker for future disease monitoring in the development of AMKL. If a GATA1 mutation is detected in a neonate without clinical features of DS, cytogenetic analysis should still be performed to exclude DS mosaicism[5].
Familial Forms
not applicable
Additional Information
Also see HAEM4:Myeloid Proliferations Associated with Down Syndrome
Links
http://www.archivesofpathology.org/doi/pdf/10.5858/arpa.2014-0304-CC?code=coap-site
https://www.ncbi.nlm.nih.gov/pmc/articles/PMC2265448/
https://www.ncbi.nlm.nih.gov/pmc/articles/PMC5031718/pdf/11899_2016_Article_338.pdf
https://link.springer.com/content/pdf/10.1007%2Fs12185-016-1959-5.pdf
https://www.ncbi.nlm.nih.gov/pmc/articles/PMC4551356/
References
(use the "Cite" icon at the top of the page) (Instructions: Add each reference into the text above by clicking where you want to insert the reference, selecting the “Cite” icon at the top of the wiki page, and using the “Automatic” tab option to search by PMID to select the reference to insert. If a PMID is not available, such as for a book, please use the “Cite” icon, select “Manual” and then “Basic Form”, and include the entire reference. To insert the same reference again later in the page, select the “Cite” icon and “Re-use” to find the reference; DO NOT insert the same reference twice using the “Automatic” tab as it will be treated as two separate references. The reference list in this section will be automatically generated and sorted.)
- ↑ 1.0 1.1 1.2 1.3 1.4 1.5 1.6 1.7 Arber DA, et al., (2017). Myeloid proliferations associated with Down syndrome, in World Health Organization Classification of Tumours of Haematopoietic and Lymphoid Tissues, Revised 4th edition. Swerdlow SH, Campo E, Harris NL, Jaffe ES, Pileri SA, Stein H, Thiele J, Arber DA, Hasserjian RP, Le Beau MM, Orazi A, and Siebert R, Editors. IARC Press: Lyon, France, p169-170.
- ↑ 2.0 2.1 2.2 2.3 Klusmann, Jan-Henning; et al. (2008). "Treatment and prognostic impact of transient leukemia in neonates with Down syndrome". Blood. 111 (6): 2991–2998. doi:10.1182/blood-2007-10-118810. ISSN 0006-4971. PMC 2265448. PMID 18182574.
- ↑ 3.0 3.1 3.2 3.3 Gruber, Tanja A.; et al. (2015). "The biology of pediatric acute megakaryoblastic leukemia". Blood. 126 (8): 943–949. doi:10.1182/blood-2015-05-567859. ISSN 1528-0020. PMC 4551356. PMID 26186939.
- ↑ 4.0 4.1 4.2 4.3 Bhatnagar, Neha; et al. (2016). "Transient Abnormal Myelopoiesis and AML in Down Syndrome: an Update". Current Hematologic Malignancy Reports. 11 (5): 333–341. doi:10.1007/s11899-016-0338-x. ISSN 1558-822X. PMC 5031718. PMID 27510823.
- ↑ 5.0 5.1 5.2 5.3 5.4 5.5 5.6 5.7 Bombery, Melissa; et al. (2014). "Transient abnormal myelopoiesis in neonates: GATA get the diagnosis". Archives of Pathology & Laboratory Medicine. 138 (10): 1302–1306. doi:10.5858/arpa.2014-0304-CC. ISSN 1543-2165. PMID 25268193.
- ↑ 6.0 6.1 Saida, Satoshi (2016). "Evolution of myeloid leukemia in children with Down syndrome". International Journal of Hematology. 103 (4): 365–372. doi:10.1007/s12185-016-1959-5. ISSN 1865-3774. PMID 26910243.
Notes
*Primary authors will typically be those that initially create and complete the content of a page. If a subsequent user modifies the content and feels the effort put forth is of high enough significance to warrant listing in the authorship section, please contact the Associate Editor or other CCGA representative. When pages have a major update, the new author will be acknowledged at the beginning of the page, and those who contributed previously will be acknowledged below as a prior author.
Prior Author(s):
*Citation of this Page: “Myeloid proliferations associated with Down syndrome”. Compendium of Cancer Genome Aberrations (CCGA), Cancer Genomics Consortium (CGC), updated 02/10/2025, https://ccga.io/index.php/HAEM5:Myeloid_proliferations_associated_with_Down_syndrome.